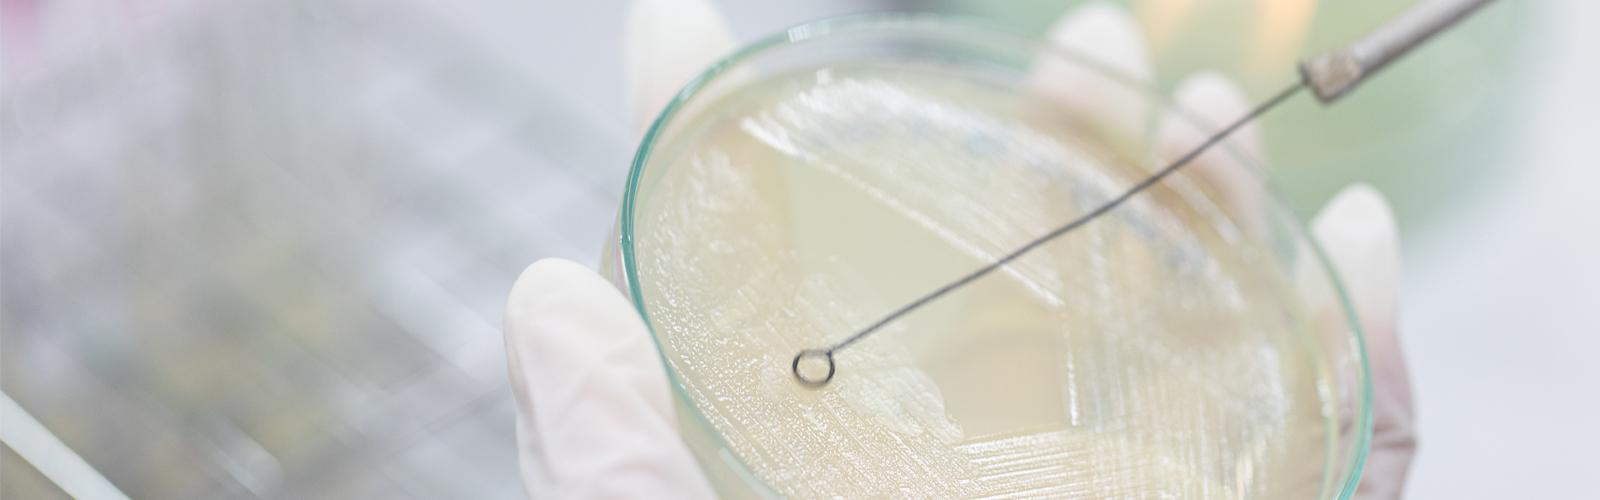

Bacteriological
Java Biocolloid’s bacteriological agar ensures accurate, reliable microbial growth, offering superior gelling performance for testing, quality control, and research.
Java Biocolloid can provide high-quality bacteriological agar that meets the strict standards required for microbiological testing and research. Our agar is specially formulated to support the growth of a wide range of microorganisms, ensuring accurate and reliable results in laboratory applications. With superior gelling properties and consistent performance, our bacteriological agar is ideal for use in culturing bacteria, fungi, and other microorganisms. Whether for routine testing, quality control, or scientific studies, we offer unmatched reliability and precision to support your laboratory needs.
Products

Agar-based gelling agent that provides a transparent medium for easy observation, acts as an inert support matrix, and features a low gelling point; ideal for microbiological and laboratory applications.

test produk agar